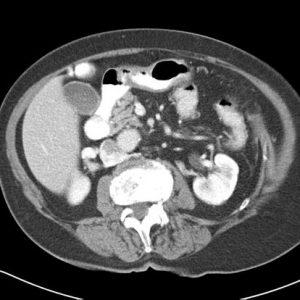
Tụy nhẫn
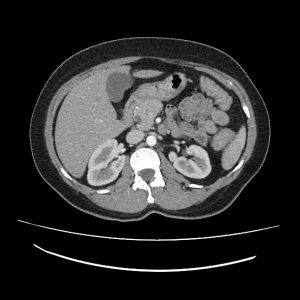
Tụy nhẫn

TIÊU HOÁ
Hiển thị 21–40 của 1445 kết quảĐã sắp xếp theo mới nhất
-

Tắc ruột
Lượt xem: 2080» 22-09-2022 -

FNH
Lượt xem: 730» 14-09-2022 -

Nhồi máu mạc nối
Lượt xem: 824» 12-07-2022 -

Nang ống mật chủ
Lượt xem: 846» 27-04-2022 -

Sỏi đường mật
Lượt xem: 1116» 19-03-2022 -

Thiếu máu mạc treo
Lượt xem: 701» 12-02-2022 -

Phình TM cửa
Lượt xem: 543» 31-01-2022 -

Túi thừa đại tràng
Lượt xem: 960» 24-01-2022 -

Ung thư đường mật
Lượt xem: 679» 31-12-2021 -

Lồng ruột
Lượt xem: 938» 24-11-2021 -

Lồng ruột
Lượt xem: 723» 24-11-2021 -

Lồng ruột
Lượt xem: 574» 24-11-2021 -

U đại tràng
Lượt xem: 823» 16-11-2021 -

Viêm túi mật cấp
Lượt xem: 803» 08-11-2021 -

Lymphoma gan
Lượt xem: 861» 01-11-2021 -

Thoát vị hoành
Lượt xem: 505» 29-10-2021 -

Tụy nhẫn
Lượt xem: 491» 23-10-2021 -

Tụy nhẫn
Lượt xem: 421» 23-10-2021 -

Tụy nhẫn
Lượt xem: 712» 23-10-2021 -

Tụy nhẫn
Lượt xem: 639» 23-10-2021